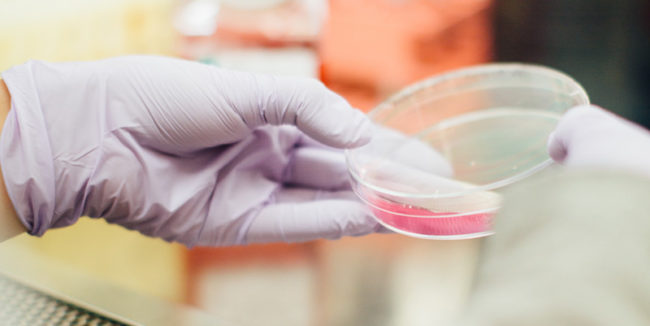

Creating and Embedding a Safety Culture in the Rail Sector
In a growth sector that is undergoing its biggest modernisation programme since Victorian times, safety continues to sit at the top of Network Rail’s priorities. Safety must be seen to be embedded at every level of an organisation if contractors are to succeed in this highly competitive sector.